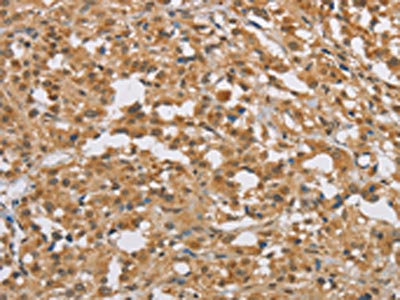

DIDO1 Antibody
-
中文名稱:DIDO1兔多克隆抗體
-
貨號:CSB-PA870531
-
規格:¥1100
-
圖片:
-
The image on the left is immunohistochemistry of paraffin-embedded Human thyroid cancer tissue using CSB-PA870531(DIDO1 Antibody) at dilution 1/50, on the right is treated with fusion protein. (Original magnification: ×200)
-
The image on the left is immunohistochemistry of paraffin-embedded Human cervical cancer tissue using CSB-PA870531(DIDO1 Antibody) at dilution 1/50, on the right is treated with fusion protein. (Original magnification: ×200)
-
-
其他:
產品詳情
-
Uniprot No.:
-
基因名:DIDO1
-
別名:DIDO1 antibody; C20orf158 antibody; DATF1 antibody; KIAA0333Death-inducer obliterator 1 antibody; DIO-1 antibody; hDido1 antibody; Death-associated transcription factor 1 antibody; DATF-1 antibody
-
宿主:Rabbit
-
反應種屬:Human
-
免疫原:Fusion protein of Human DIDO1
-
免疫原種屬:Homo sapiens (Human)
-
標記方式:Non-conjugated
-
抗體亞型:IgG
-
純化方式:Antigen affinity purification
-
濃度:It differs from different batches. Please contact us to confirm it.
-
保存緩沖液:-20°C, pH7.4 PBS, 0.05% NaN3, 40% Glycerol
-
產品提供形式:Liquid
-
應用范圍:ELISA,IHC
-
推薦稀釋比:
Application Recommended Dilution ELISA 1:2000-1:10000 IHC 1:100-1:300 -
Protocols:
-
儲存條件:Upon receipt, store at -20°C or -80°C. Avoid repeated freeze.
-
貨期:Basically, we can dispatch the products out in 1-3 working days after receiving your orders. Delivery time maybe differs from different purchasing way or location, please kindly consult your local distributors for specific delivery time.
-
用途:For Research Use Only. Not for use in diagnostic or therapeutic procedures.
相關產品
靶點詳情
-
功能:Putative transcription factor, weakly pro-apoptotic when overexpressed. Tumor suppressor. Required for early embryonic stem cell development.; Displaces isoform 4 at the onset of differentiation, required for repression of stemness genes.
-
基因功能參考文獻:
- Results identified a novel pH-dependent mechanism by which epigenetic reader, the PHD fingers of DIDO, recognize the histone mark H3K4me3. The pH-sensing ability might be necessary for normal biological processes and those characterized by altered cellular pH. PMID: 28919441
- evaluated the Death Inducer-Obliterator (DIDO) (variants DIDO 1, 2 and 3) levels in CML, PV, ET and PMF patients. Our data reported the DIDO 1, 2 and 3 differential expressions in Myeloproliferative Neoplasms. PMID: 27282563
- Dido1 induces the expression of Integrin alphaV, thereby promoting the attachment, migration, invasion and apoptosis resistance of melanoma cells. PMID: 22469980
- Data show that CSE1L, DIDO1 and RBM39 mRNA expression levels correlated with chromosome 20q DNA copy number status. PMID: 22711543
- Gambogic acid induces the apoptosis of Raji cells through DIO-1 upregulation, nuclear translocation, Bcl-xL downregulation and caspase 3 activation. PMID: 19236754
- Data suggest that Dido might be one of the tumor suppressor genes at chromosome 20q and that the Dido-targeted mouse may be a suitable model for studying myeloproliferative diseases and myelodysplastic syndromes. PMID: 16127461
- Dido3, the largest splice variant of the Dido gene, is a centrosome-associated protein whose disruption leads to supernumerary centrosomes, failure to maintain cellular mitotic arrest, and early degradation of the mitotic checkpoint protein BubR1. PMID: 17299043
- Gambogic acid induces DIDO1-mediated apoptosis in Jurkat T cells. PMID: 18298900
顯示更多
收起更多
-
亞細胞定位:Cytoplasm. Nucleus. Cytoplasm, cytoskeleton, spindle.
-
組織特異性:Ubiquitous.
-
數據庫鏈接:
Most popular with customers
-
-
YWHAB Recombinant Monoclonal Antibody
Applications: ELISA, WB, IHC, IF, FC
Species Reactivity: Human, Mouse, Rat
-
Phospho-YAP1 (S127) Recombinant Monoclonal Antibody
Applications: ELISA, WB, IHC
Species Reactivity: Human
-
-
-
-
-